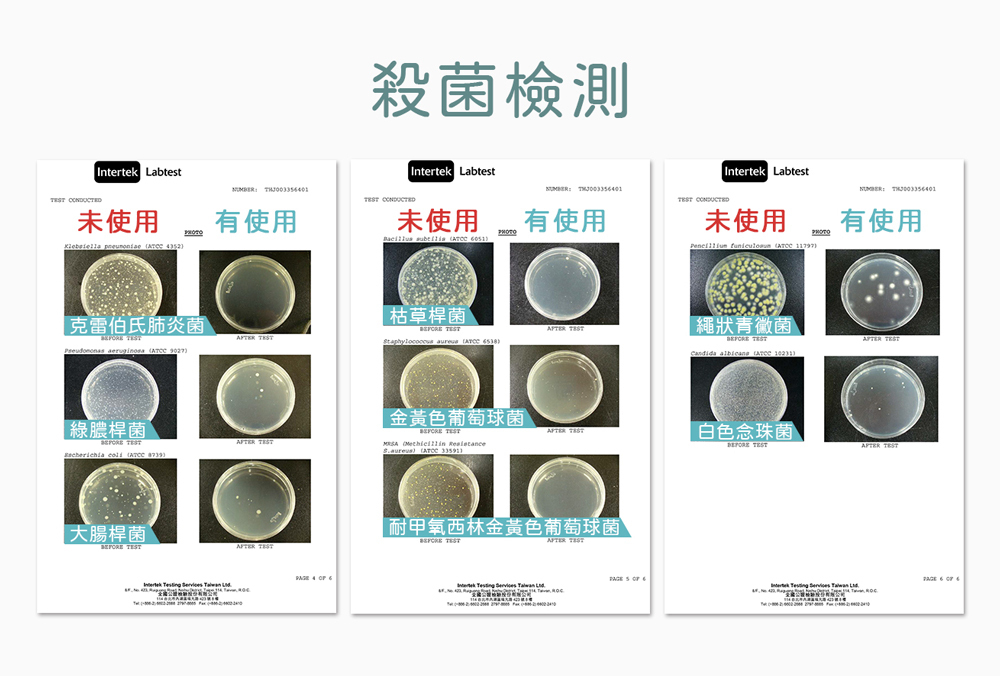

{{ 'fb_in_app_browser_popup.desc' | translate }} {{ 'fb_in_app_browser_popup.copy_link' | translate }}
{{ 'in_app_browser_popup.desc' | translate }}
- 4顆鹼性電池供電
-易於使用的便攜式紫外線消毒棒
-安全設計,紫外線燈在消毒過程中旋轉 90 度後自動關閉
至2026-03-31T16:00:00.000+00:00截止 全店,女王寵愛月|全館滿 $3300折$300
全店,全館消費滿NT$1,000,即享免運優惠 (不含離島地區和冷凍商品)
全店,全館冷凍消費滿NT$1,500,即享免運優惠 (不含離島地區)
商品存貨不足,未能加入購物車
您所填寫的商品數量超過庫存
{{'products.quick_cart.out_of_number_hint'| translate}}
{{'product.preorder_limit.hint'| translate}}
每筆訂單限購 {{ product.max_order_quantity }} 件
現庫存只剩下 {{ quantityOfStock }} 件